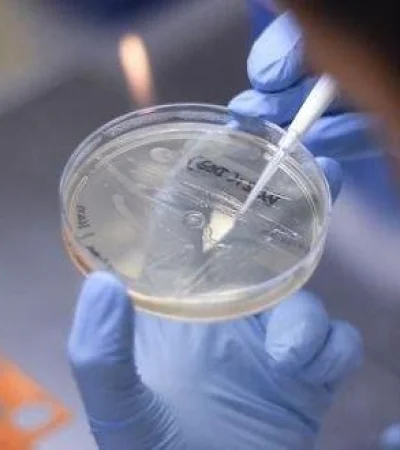
VARIANTES

Ante la alerta por una nueva variante de Brasil, San Pablo respondió
Desde la Secretaría de Salud desestimaron una nueva cepa y explicaron el porqué
26 Mayo de 2021 - 21:14
26 Mayo de 2021 - 21:14
26 Mayo de 2021 / Ciudadano News / COVID-19
En los últimos meses se dieron a conocer distintos tipos de variantes del coronavirus en todo el mundo, ya se conocen: la británica, la India, Manaos, y la sudafricana. En tanto desde hace algunas horas, comenzaron las repercusiones sobre una posible nueva cepa que se habría originado en Brasil.
Desde el Gobierno del estado de San Pablo, principal foco de coronavirus en Brasil, desestimaron por el momento la importancia de un estudio universitario que describió la existencia de una nueva variante del virus en dos municipios del estado.
"Hasta el momento no hay notificación oficial de una variante P4", como fue llamada en el estudio, dijo la Secretaría de Salud paulista en un comunicado.
Los laboratorios públicos son los que determinan oficialmente si una nueva variante viral, de las cientos que circulan, es extraordinaria y debe ser tenida en cuenta por su posible mayor contagiosidad. Asimismo, la Secretaría de Salud de San Pablo informó que "hay cientos de variantes de coronavirus en todo momento y tres de ellas actualmente son consideradas variantes de atención debido al aumento de contagio o gravedad de la infección, como las variantes P.1, B.1.1.7 y B.1.351".
Según estudios, los especialistas indicaron en estos meses que estas cepas nuevas de COVID-19, son mucho más infecciosas y contagiosas. A pesar de esto, desde el país vecino especificaron que la detección de nuevas variantes "no debe ser confundida con diagnóstico ni puede ser considerada en forma aislada". Por que como indicaron son consideradas variantes o cepas de riesgo cuando hay transmisión considerable.
"La principal razón es que cuando los científicos identifican y ponen nombre a una nueva variante es porque ya lleva circulando semanas o meses, sobre todo en países donde se secuencia muy poco", informó a Télam el biólogo Jiménez Guardeño, investigador del Departamento de Enfermedades Infecciosas del prestigioso instituto en Londres
¿Qué se sabe entonces de esta variante?
La variante denominada P4 fue descrita en un trabajo publicado ayer por la Universidad Estadual de Sao Paulo (Unesp) que dijo que circulaba en los municipios de Porto Ferreira, interior paulista, que tuvo en mayo su pico de muertes, y de Mococa.
En tanto, el vicepresidente de la Sociedad Brasileña de Virología, Joao Pessoa Araújo Junior, dijo al sitio G1 que el 17,9% de los casos de Porto Ferrerira se deben a esta variante P4, aunque no pudo determinar si puede ser considerada con importancia mayor, por lo que todavía no se estabelcen comunicados oficiales al respecto, y no confirman su detección.
Brasil detectó la variante sudafricana en el interior de San Pablo, en la ciudad de Sorocaba, y registró la presencia de la variante de India en las últimas horas, y se le atribuye a la cepa de Manaos, la P1, el estrago causado en la segunda ola de coronavirus.